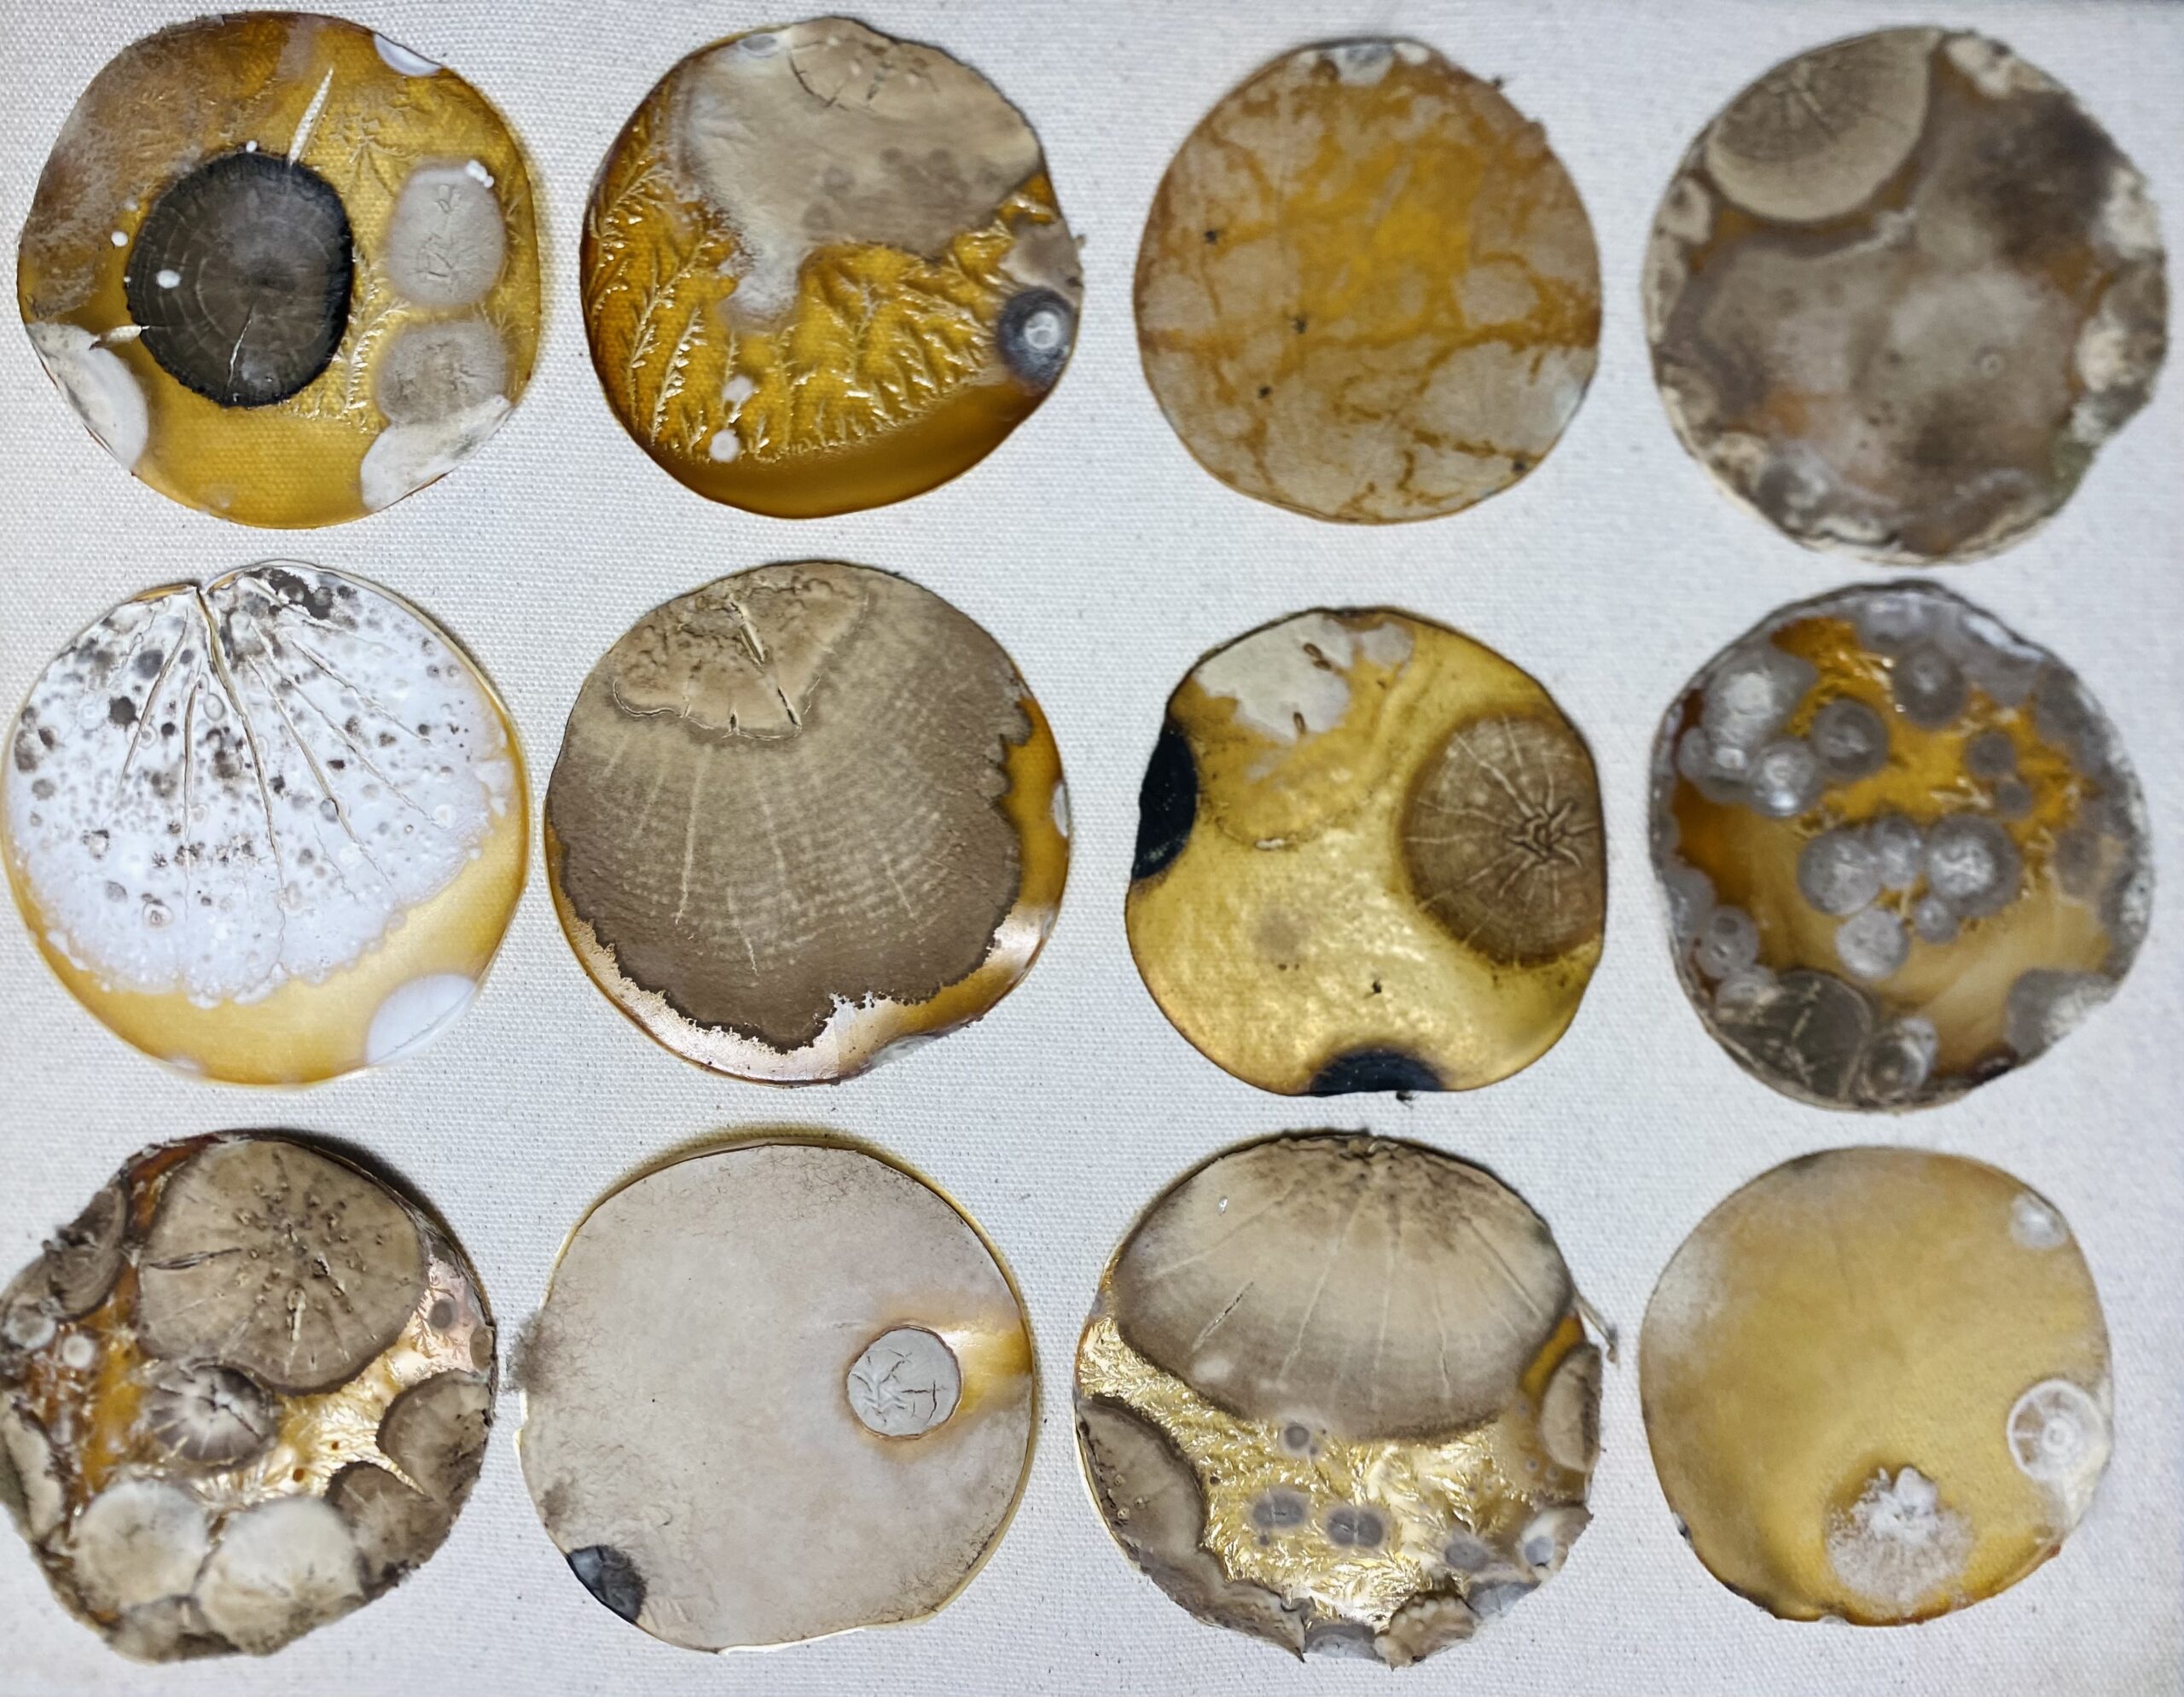

Clikea EN bio/RSS
https://www.instagram.com/juan_sebastian_gonzalez/?hl=es
«En todo paseo con la naturaleza uno recibe mucho mas de lo que busca.» – John Muir.
DETENERSE, VALORAR y CREAR con la NATURA
La naturaleza no es solo un lugar fuera de la ciudad. Esta en todas partes. Aqui mismo; en todo. Y el arte es una forma de entenderla, de explorarla, de mirarla.
Desde este aqui y ahora cercano a nosotros y en sintonia con otros con- textos mas alejados, nace esta exposicion. Investigaciones centradas en el concepto de la geografia sensorial, fisica, cultural y cientifica de la Sierra de Aracena junto con la provincia de Salamanca y que se centra en las relaciones basicas (que no dejan de ser complejas) con el paisaje, incidiendo en el territorio, con sus conformaciones visuales, con sus diversos y ricos ecosistemas que sustentan una forma de vida.
No podemos imaginar el mundo del arte contemporaneo como un paisaje que contemplamos de manera panoramica, a traves de una vision univoca y continua “de izquierda a derecha”, como si este se tratase de un territorio delimitado y fronterizo, con unos habitantes (humano, flora, fauna…) y paisajes estables. Es un sentido erroneo, pues de hecho se caracteriza por sus interferencias y entrecruzamientos, por sus discontinuidades, grietas, e impulsos, por su devenir paralelo en muchos casos entre distintas areas. Esta muestra no es la forma tradicional de entender y mostrar el paisaje, es una nueva lectura y propuesta. Es un ejercicio que queremos provocar y poner en evidencia en cualquier caso como un lugar especifico de experimenta- cion, pues el proceso y resultado del trabajo realizado por ambos artis- tas nos llevan a un trampantojo de texturas, materiales, visiones y abismos que conforma el mundo y sentir del arte contemporaneo con consciencia ambiental, donde es facil extraviarse como subitamente experimentar una revelacion, invadido como esta por deformaciones, agujeros negros, confusiones…o desconocimiento. El mundo del arte contemporaneo es en realidad no uno sino muchos mundos.
Estos dos artistas nos presentan no solo la trama de su trabajo creativo intimo sino todo un territorio geografico natural estudiado, recorrido con rigor, donde se detienen conscientemente recreando de forma diferente y en dialogo el valor de este. Trabajar dos regiones (en relacion historica y cientifica como es la Ruta de la Plata), nos lleva a viajar por paisajes culturales y naturales muy distintos a traves del trabajo artistico, documental, y tecnologico y donde aun es posible recibir una impresion de una vida sencilla, humilde, desde la quietud e intensa belleza de la naturaleza. Relatar, visibilizar y revelar visualmente una realidad a la que debemos volver.
Detenerse en el territorio, en el paisaje y sus moradores. En definitiva, pues lo no humano, el pos humanismo, el capitalismo emocional, la teoria de afectos, las intimidades frias, la falta de futuros, los malestares y patologias psicologicas aparecen una y otra vez bajo falsas apariencias, creo que es hora de erradicarlo y profundizar en la esencia, llegar a las raices de donde procedemos, de la madre tierra, de su sabiduria y generosidad para continuar despiertos.
Vision centrada en los ultimos años de la contemporaneidad, del resurgir de la consciencia natural, el arte de la TIERRA, (Land Art-Earth Work) y en lo que de trascendente tiene el presente medioambientalmente desde las areas rurales. Juan Sebastian Gonzalez realiza una revision tematizada e introspectiva del paisaje, desde la actualizacion y memoria botanica a la intervencion directa o specific-site en tiempo real, conversando y visibilizando ciertos aspectos decisivos para crecer como humanos y proteger el territorio natural. Desde ellas, y en relacion con la tradicion, el pasado y la herencia cultural, hacemos posible la realidad. En esta posicion intersticial hay una posibilidad que ha sido poco explorada, que es la de hacer VISIBLE la profunda interdependencia de todo lo que nos rodea y conforma. Esta exposicion es una toma de tierra, con fuerte impronta de etica y estetica, desde un activismo artistico que nos lleva a reflexionar sobre importantes cuestiones globales que se estan obviando.
RESCATAR lo poeticamente invisible, lo sublime, el proceso y los elementos naturales como materiales que conforman la obra, la fragilidad poderosa de los elementos, y situan las practicas contemporaneas del arte ambiental para preguntarnos desde el origen, al papel de la cultura como mediadora entre lo heredado y lo necesariamente actualizado, y tambien, entre la humanidad y el entorno en el que vivimos y al que modelamos con nuestro habitar y nuestras interacciones, registrando trasversalmente el acontecer natural de este nuevo siglo con sus miradas.
Despues de recorrer y descubrir esta propuesta me gustaria que nos hagamos esta pregunta:
¿Que podemos legar, y que futuro le dejamos a las generaciones venideras?
Veronica Alvarez / Curadora, gestora cultural Directora del Centro de Arte Contemporaneo Medioambiental VALDELARTE CACM
Intervencion en el RIO TINTO (Huelva) 2022